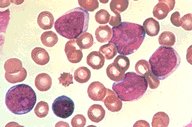

Description
ALL L2: This low oil magnification view of the Wright's stained
peripheral blood shows five blasts of the L2 type surrounding a
lymphocyte. It can be seen that these blasts are somewhat larger
and more variable in morphology.
|
|
Click on this image
to enlarge it, then
on Back buttom
in the Netscape Menu
to shrink it back down



|